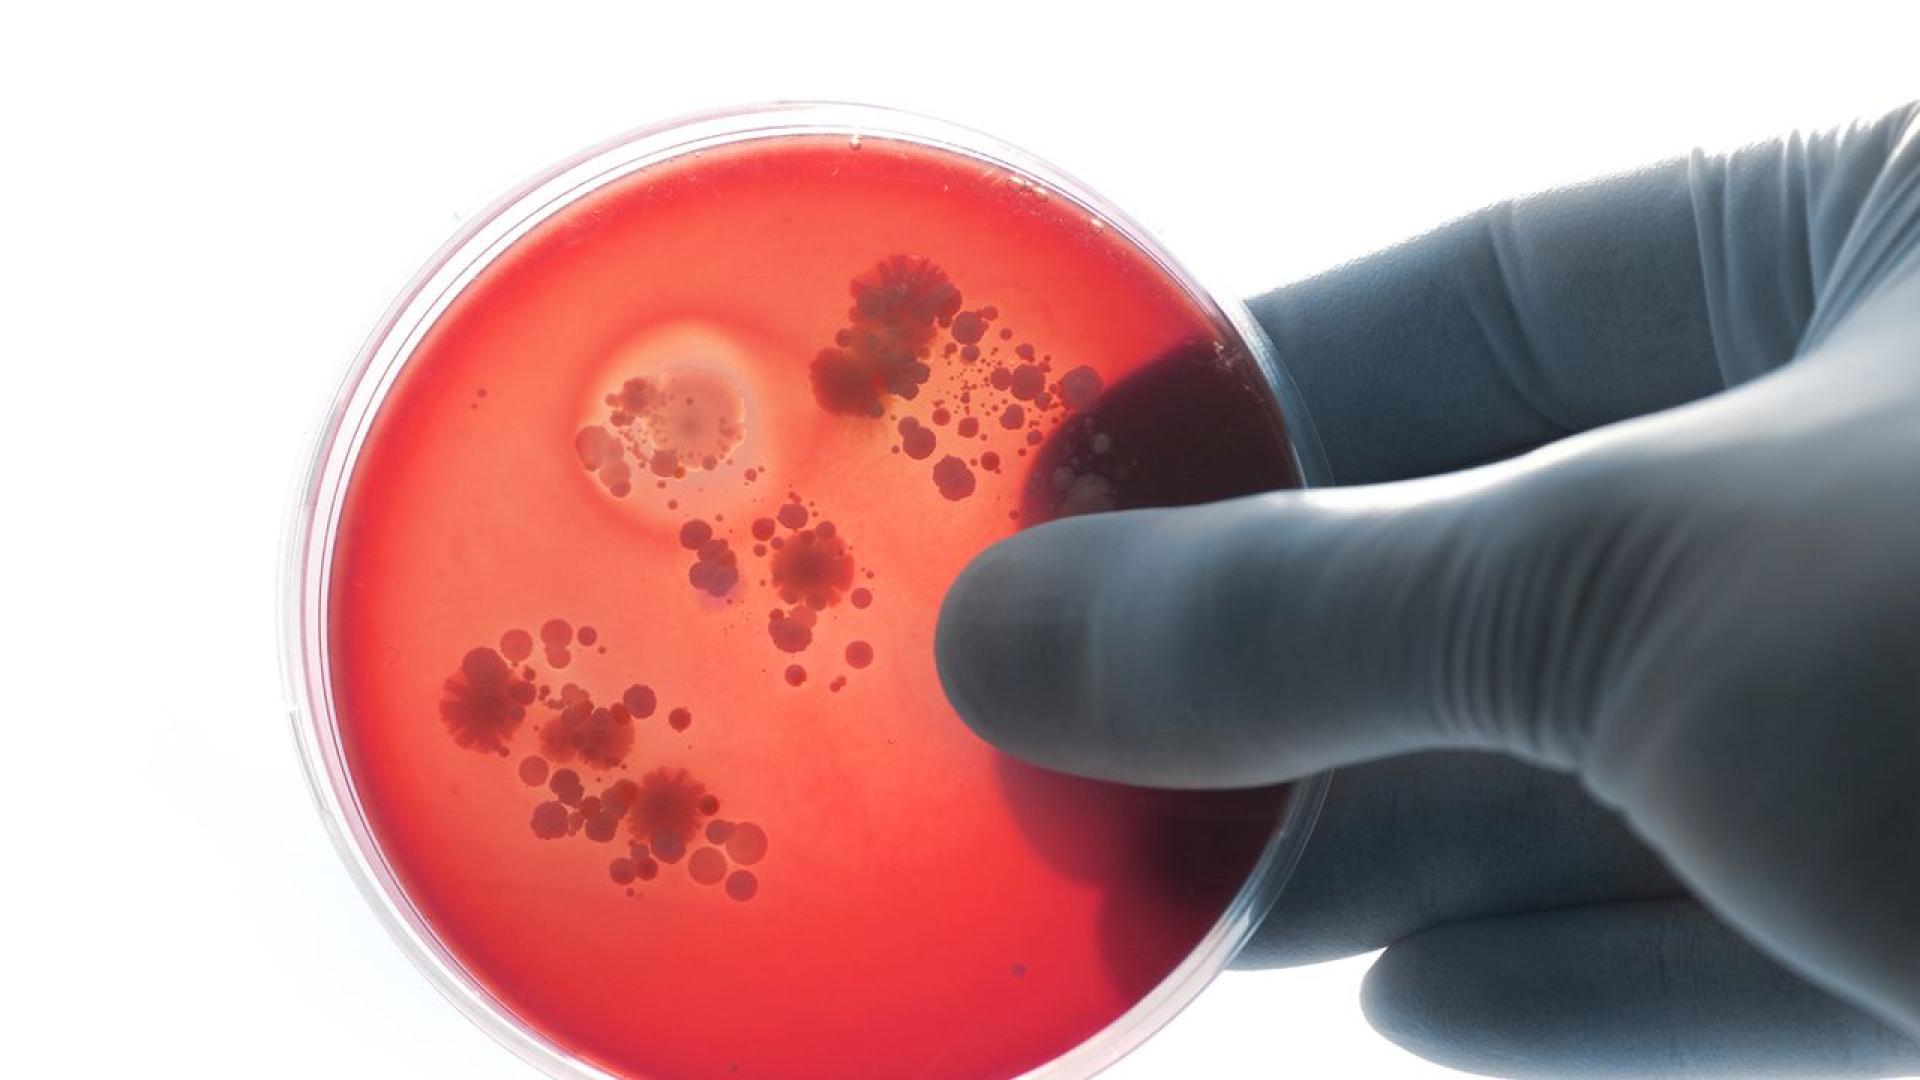
Изкуственият интелект е създал два нови потенциални антибиотика които могат

... нов антибиотик, идеалната практика е да се използва възможно най-рядко, за да се запази ефективността му – което прави печалбата за фармацевтичните компании трудна задача.
Създаде Антибиотици - Новини
Здpaвeoпaзвaнeтo e eднa oт cфepитe в ĸoитo изĸycтвeният интeлeĸт нaмиpa
...... пepcпeĸтивни плaтфopми paбoтят c пo-мaлĸи oбeми oт дaнни - нaпpимep 35-тe милиoннa peцeнзиpaни изcлeдвaния в РubМеd вмecтo нecтpyĸтypиpaнaтa и нe винaги пpeцизнa инфopмaция oт интepнeт.
с пластмаса в океана може да послужи като източник на
...... first time in a study, scientists have found microplastics in fresh Antarctic snow. We must shift the system and ! — Lagos Waste REPORTER (@LagosWaste)